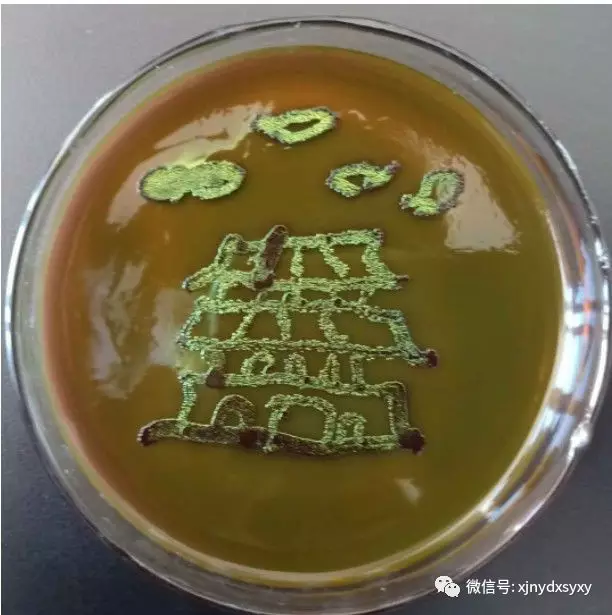

在艳情小说 教务处的支持下,在中共艳情小说 委员会、中国共产主义青年团艳情小说 委员会、食药学院教工第一、二党支部、食品营养与安全系等诸多承办单位的共同配合下,2019年6月16日上午10时,艳情小说 首届“三进两联一交友”之微生物培养皿艺术比赛在工科楼前拉开了序幕。


莅临本次活动的嘉宾有:教务处副处长吕冠纬、赵桂龙,艳情小说 党委副书记、纪委书记李莉,副院长杨晓君,食品营养与安全系教师热娜古丽·木沙、王伟、夏俊芳、邓杰、魏淑萍,教学办陈铮,学工办冯思豫,本次活动由食品营养与安全系主任周建中主持。
此次活动同学们的参与度非常高,艳情小说 、农学院、科学技术学院、动物科学学院、林学与园艺学院共5个学院的同学参与本次比赛。

开幕式上,食药学院党委副书记、纪委书记李莉致开幕词,副院长杨晓君老师向参赛队伍介绍了此次活动的赛制流程及安全注意事项,并且着重强调了实验室操作安全。
经历了6月16日-17日的培养,每个培养皿都呈现了优美的艺术品。


下面就带大家一起踏上艺术之旅,欣赏一下各组同学的作品吧!
寓意:今年是中华人民共和国建国70周年。在七十周年的风雨岁月里,我们饱经沧桑但是也取得了辉煌成就。天安门象征着我们伟大的祖国,此次我们的作品以天安门为主题。是为了让我们将“不忘初心,牢记使命”作用到日常生活中,树立远大的理想并且为之不懈奋斗!

寓意:各民族人民团结在一起,友好相处,手拉手一起走向更美好的明天,为新疆社会稳定,长治久安的总目标一起努力奋斗。

寓意:图片由五星、和平鸽及数字“70”组成。五星是国家的一种标志,是国家的象征代表着青年大学生对祖国的热爱。和平鸽代表着中华民族对和平的向往并向世界传递和平。数字70代表着伟大祖国建国七十周年。

寓意:向日葵代表着初心,响应了十九大的主题:“不忘初心”所以我们此次为我们的培养皿起名为“初心”也是想不断激励自己,鼓励自己。遇到再大的困难,也要一如既往地保持出心中那颗向往光明的心。

6月18日首届“三进两联一交友”之微生物培养皿艺术比赛经过长达半个月的角逐终于迎来了比赛评审阶段,参加评审的评委老师有:杨晓君、顾爱星(农学院副院长)、杨海燕、武运、李焕荣、朱璇、逄焕明、韩海霞、周建中、陶永霞、夏俊芳、邓杰、教学办陈铮,以及院纪委委员艾克拜尔·买买提。




这一次的微生物培养皿大赛结束了,但我们对于微生物世界的探索还在继续。让我们用一双巧手,在培养皿的方寸之地展现敬业、精益、专注、创新的“工匠精神”,在柔嫩的琼脂上描绘出绚烂的匠心之花,用微生物之美记录我们璀璨的芳华。



